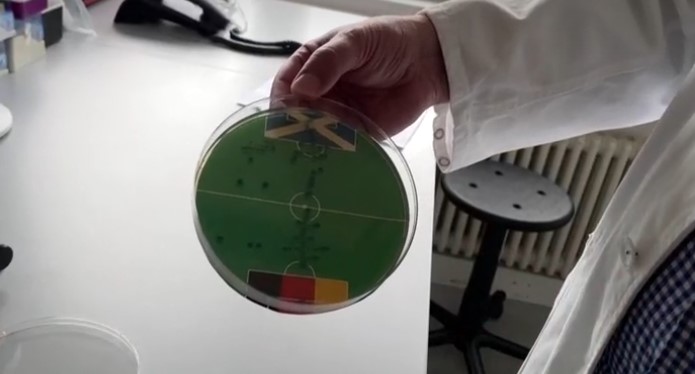

Не е чудно што толку многу луѓе избираат мачка за свој дневен придружник
Љубителите на мачки сигурно ќе се согласат со нас. Не е чудно што толку многу луѓе избираат мачка за свој дневен придружник. Мачките се животни кои ни помагаат да бидеме ментално и физички поздрави и, како што покажаа некои студии, нè прават подобри луѓе.
Мачките се животни кои ни помагаат да се дружиме повеќе и да го зголемиме бројот на нашите социјални интеракции. Може да забележите дека странците се со поголема веројатност да се поздрават, да се насмеат, па дури и да започнат разговор кога сте околу вашата мачка.
Поголемиот дел од времето кога споделувате смешна приказна за вашата мачка, луѓето веднаш ги раскажуваат своите искуства. Овие кратки социјални интеракции прават да се чувствуваме повеќе поврзани со заедницата.
Студијата на Американското здружение за срце заклучи дека сопствениците на домашни миленици имаат намален ризик од развој на кардиоваскуларни болести, вклучувајќи висок холестерол, висок крвен притисок и дебелина.
Исто така, постојат студии кои покажуваат дека сопствениците на мачки имаат помала веројатност да доживеат срцев удар или мозочен удар отколку луѓето кои немаат мачка, пишува Петси.
Мачките повеќе би сакале да бидат со луѓе што ги сакаат отколку да јадат, покажува студијата
Интеракцијата со мачки, исто така, помага во ослободување на серотонин и допамин, кои се корисни за намалување на стресот, регулирање на расположението и на крајот подобрување на вашиот имунолошки систем.
Исто така, вашата мачка ќе ви помогне да останете активни, што е уште еден здравствен плус. Секој знае дека секој вид на вежбање е добар за вашето здравје, а мачките можат да ни помогнат да бидеме активни барем неколку минути секој ден.
Една интересна студија од Државниот универзитет во Орегон покажа дека мачките повеќе сакаат да бидат со своите луѓе отколку да јадат. Помеѓу храната и драгата личност, мачките најчесто избирале драги луѓе, пренесува Index.hr.
Се чини дека нашите миленици навистина не сакаат, но понекогаш имаат тенденција да бидат многу ноншалантни во врска со тоа.

GIPHY App Key not set. Please check settings